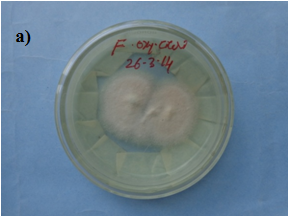
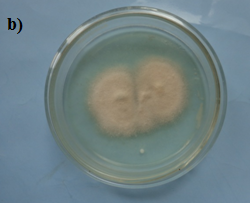
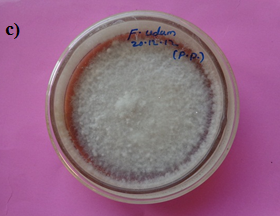
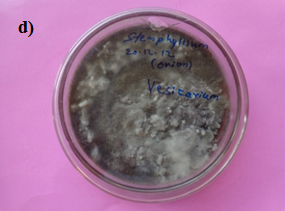
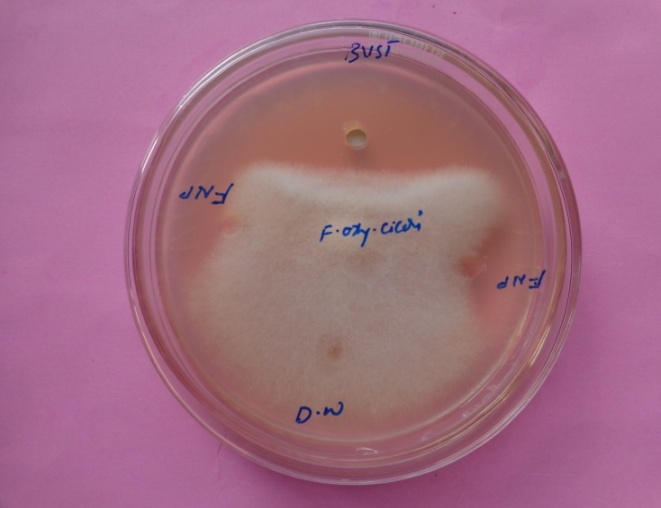
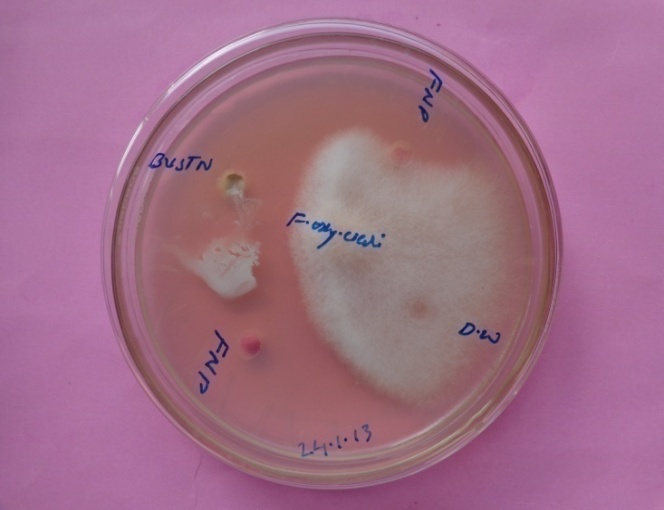

Mycology and Plant Pathology Laboratory, Department of P. G. Studies and Research in Botany, Gulbarga University, Gulbarga 585106, Karnataka, India
Email: ravindrakeluskar@gmail.com
Received: 29 Jan 2015 Revised and Accepted: 24 Feb 2015
ABSTRACT
Objective: Evaluation of antifungal activity of silver nanoparticles synthesized using different fungal species
Methods: Fungus like Fusarium oxysporum, Fusarium udum, Fusarium oxysporum and Stemphylium vericans were used for the synthesis of silver nanoparticles. The synthesis was characterized using UV-vis spectroscopy, X-ray diffraction, and transmission electron microscopy. Further, the synthesized silver nanoparticles was evaluated for antimicrobial activity by well diffusion against the pathogenic fungus.
Results: The present study, report on the biosynthesis and antifungal effect of silver nanoparticles (AgNPs) using fungal species such as Fusarium oxysporum, Fusarium udum, Fusarium oxysporum and Stemphylium vericans. The UV-vis absorbance maxima between 400-490 nm indicate the synthesis of nanoparticles. Further, transmission electron microscopy images shows spherical shape nanoparticles of size range (36-45 nm). Synthesized AgNPs showed active antifungal activity against the isolated plant pathogenic fungi. The study reveals the use of different fungal species for AgNPs synthesis exhibits a good antifungal effect which helps us to control pathogenic fungi in the near future.
Conclusion: A simple, cost effective method was developed in the present study; the synthesized silver nanoparticles was spherical in shape of size range 36-45 nm which showed good antifungal activity.
Keywords: Silver nanoparticles, UV-vis spectroscopy, Antifungal effect.
INTRODUCTION
Small is beautiful and small is powerful”, the important statement holds well when we talk about nanoparticles. Nanoparticles, generally considered as particles with a size of up to 100 nm, exhibit completely new or improved properties as compared to the larger particles of the bulk material that they are composed of [1]. Various physical and chemical techniques have been used successfully to produce nanoparticles, but these methods involve the use of hazardous chemicals which pose potential environmental and biological risks [2]. In contrast, biological methods urged as safe, cost effective, possible eco-friendly alternatives to physical and chemical methods [3]. For several decades, silver (Ag+) has been studied for use in the disinfection of various harmful microorganisms [4, 5] One of the potential applications of silver is in management of plant diseases. Silver displays multiple modes of inhibitory action against microorganisms [6]; therefore, it may be used with relative safety for control of various plant pathogens, compared to synthetic fungicides [7]. Primary requirements for the potential use of silver in control of plant disease include the need for more information on the antifungal activity of various silver compounds to plant pathogens and development of better application strategies to increase the efficacy of disease suppression [8]. Findings from some studies have demonstrated that bulk silver in an oxygen-charged aqueous media will catalyze complete destructive oxidation of microorganisms. However, board use of silver as a powerful clinical tool remains to be understood [9].
Fungi are the best candidates in the synthesis of metal nanoparticles, because of their ability to secrete a large amount of enzyme [10] and easy to store and isolate from different sources like soil, air, plants, etc., In this experiment we have used four different fungal strain such as Fusarium oxysporum, Fusarium udum and Stemphylium vericans for biological synthesis of silver nanoparticles and their antifungal effect. These fungi were commonly found in marshland and the local environment, hence we have undertaken these fungi for investigation. The present study includes time dependent formation of silver nanoparticles and characterization employing UV-vis spectrophotometer, TEM, X-ray diffraction (XRD), and accessing antifungal effect.
MATERIALS AND METHODS
Media and chemicals
Potato dextrose agar (PDA), Silver nitrate, lacto phenol cotton blue stain, Czepak-dox Broth
Methodology
Sample collection
Infected onion, wilted chick pea, pigeon pea and sorghum seeds were collected from Sirgapur Tq. Dist. Gulbarga, Samples were transferred into sterile plastic bags and brought to Mycology and Plant pathology Laboratory and stored in laboratory conditions for further investigation
Isolation and inoculation
Sorghum seeds, wilted stem of chick pea and pigeon pea were surface sterilized by running water and broken longitudinal kept in the moist blotter for growth of the fungi, after two days associated fungi were isolated and identified as Fusarium oxysporum, Fusarium udum, Fusarium oxysporium and Stemphylium vericans with the help of published literature. Fusarium oxysporum isolated from chick pea, Fusarium udum from pigeon pea, Stemphylium vericans from onion and Fusarium oxysporium. From sorghum seeds, isolated fungi were further sub cultured on PDA plates (fig. 1) and slants in order to obtain a pure culture. Pure isolates were inoculated to 250 ml conical flask containing 100 ml liquid media Czepak-dox broth, the flask was kept on rotator orbital shaker for seven days at 120RPM. Thereafter cultured material sieved by funnel separating media content. The biomass, thus obtained was inoculated in 250 ml conical flask containing 100 ml sterilized distilled water and kept for 3 days on rotator shaker for agitation at the speed of 150 rpm. After the incubation, the cell filtrate was collected and used for the synthesis of nanoparticles.
Biosynthesis of AgNPs
The fungi Fusarium oxysporum, Fusarium udum, Fusarium oxysporum and Stemphylium vericans was selected for the production of AgNPs. 10 ml culture filtrate of the fungi was mixed with 50 ml of 1 mM silver nitrate solution in 250 ml conical flask and agitated at room temperature; control (without silver nitrate, only biomass) was also run along with an experimental flask. After beginning and 72 h of time interval culture filtrate and silver nitrate turned into brown (fig. 2) due to reduction of silver nitrate to silver ions.

Fig. 1: Shows colony morphology of a) Fusarium oxysporium, b) Fusarium oxysporium, c) Fusarium udum and d) Stemphylium vricans

Fig. 2: Biosynthesis of silver nanoparticles
Characterization of synthesized Ag NPs
UV-Visible spectroscopy
The reduction of silver ions was confirmed by testing the supernatant by UV-visible spectrophotometer. The UV-visible spectroscopy measurements were performed on Elico spectral photometer as a resolution of 1 nm from 300 to 800 nm.
X-ray diffraction (XRD) study
Powdered sample was used for XRD; The Coherently diffracting Crystallography domain size of the silver nano particle was calculated from the width of the XRD peaks using scherrer formula.
(Transmission electron microscopic) TEM analysis
The TEM analysis was performed at IIT Mumbai. TEM technique was employed to see the size and shape of the synthesized silver nanoparticles.
Antifungal activity
The antifungal activity of AgNPs was investigated by well diffusion method. Potato dextrose agar plates were prepared, sterilized and solidified, after solidification fungal culture was inoculated on the plates. 2 µml, 3 µml AgNP was poured in the wells and kept for incubation at room temperature for five days. A zone of inhibition measured and compared with the standard bavistin and silver nitrate solution.
RESULTS AND DISCUSSION
UV-vis spectroscopy
Four different fungal species were screened for biological synthesis of AgNPs. 10 ml culture filtrate was treated with 1 mm silver nitrate in 250 ml conical flask the reduction of silver ion into Ag during exposure to culture filtrate fungi was followed by changing color, colorless to brown (fig. 2). It is known that AgNPs exhibits brown color in aqueous solution due to excitation of surface plasmon resonance [11]. Interestingly, culture filtrate of fungi changed the color from colorless to dark brown.
The UV-vis spectroscopy showed maximum absorption at 420, 428, 425 and 430 respectively (table1 and fig. 3).
Table 1: UV-vis spectrum analysis show time interval for changing color of different fungal species
| Fungi | Time taken for the reduction. | UV-vis peaks in nm | Color | Nature |
| Fusarium oxysporum | 60 seconds | 420-480 | Colorless-brown | Crystalline |
| Fusarium udum | 60 seconds | 430-480 | Colorless-brown | Crystalline |
| Fusarium oxysporum | 300 seconds | 420-470 | Colorless-brown | Crystalline |
| Stemphylium vericans | 300 seconds | 430-490 | Colorless-brown | Crystalline |


Fig. 3: shows the UV-Vis spectrum of AgNPs synthesized using Fusarium oxysporum, Fusarium udum, Fusarium oxysporium and Stemphylium vericans. UV-Vis spectra recorded as a function of time of reaction of an aqueous solution of 1 mm silver nitrate solution with the fungal biomass filtrate. The time of reaction is indicated next to the respective curves
XRD study
Obtained AgNPs were purified by repeated centrifugation at 3500 RPM for 40 minutes by re dispersing AgNPs pellet in 10 ml double distilled water. After drying AgNPs in the room temperature structure and composition analysis was carried out by XRD. (Table2 and fig. 4) The crystalline domain size was calculated by the width of the XRD peaks using scherrer formula D=0.96 ƛ/β cos θ, where D is crystalline domain size perpendicular to reflecting planes, ƛ is the x-ray wavelength, β is the full width at half maximum and θ is the diffraction angle. The average particle size was 30-45 nm.

XRD analysis, peaks assigned to the corresponding diffraction signals (111), (200), (220) and (311) facets of silver. The mean particle diameter of silver nanoparticles was calculated from the XRD pattern according to the line width of the (111) plane.
Table 2: X ray diffraction (XRD) analysis shape and size of the AgNPs
| Fungi | XRD peaks in nm | Shape of silver nanoparticles | size of silvernanoparticles |
| Fusarium oxysporum | 15, 30, 35, 65, 80. | Crystalline | 45 nm |
| Fusarium udum | 15, 30, 39, 60. | Crystalline | 36 nm |
| Fusarium oxysporum | 15, 30, 35, 50, 65. | Crystalline | 39 nm |
| Stemphylium vericans | 15, 30, 35, 45, 70. | Crystalline | 39 nm |

Fig. 4: shows the XRD analysis, peaks assigned to the corresponding diffraction signals (111), (200), (220) and (311) facets of Silver. The mean particle diameter of AgNPs was calculated from the XRD pattern according to the line width of the (111) plane, refraction peaks using the scherrer equation. The calculated average particle size of the silver was found to be 35-48 nm
TEM analysis
TEM technique was employed to see the size and shape of the synthesized silver nanoparticles; it is observed that there is variation in the particle sizes around 45% of particles in 20 nm range and 25% in 28 nm range and 10% in 30 nm ranges.
The particles range from 12 nm least to 75 nm high, the TEM image suggests that the particles are poly dispersed (table 3 and fig. 5) and were round in shape.
Antifungal activity
The AgNPs possess antifungal activity against isolated fungi at a concentration of 5 mg/ml. The AgNPs were compared favorably with standard bavistin at a concentration of 0.50 and 0.75 ml (table 4, fig. 6). AgNPs exhibited positive effects inhibiting the growth of tested fungi, the MIC of AgNPs was tested against which varied from 0.50 to 0.75 mg/ml whereas bavistin showed 0.60 to 80 mg/ml. The results indicated that biosynthesized AgNPs has a positive antifungal effect.
Table 3: TEM analysis shape and size of the AgNPs
| Fungi | Shape of silver nanoparticles | size of silver nanoparticles |
| Fusarium oxysporum. cicers | Spherical | 10%=75 nm, 15%=12 nm10%=36 nm 25%=28 nm40%=20 nm |
| Fusarium udum | Spherical | 5%=75 nm, 20%=12 nm8%=35 nm, 20%=28 nm47%=20 nm. |
| Fusarium oxysporum | Spherical | 60%=20 nm, 20%=28 nm8%=30 nm, 12%=12 nm |
| Stemphylium vericans. | Spherical | 10%=60 nm, 30%=30 nm40%=45 nm, 20%=25 nm |




Fig. 5: show transmission electron microscopic photographs of synthesized AgNPs from Fusarium oxysprum, Fusarium oxysporium, and Fusarium udum and Stemphylium vericans
Table 4: Antifungal activity wells method
Fungi |
Zone of Inhibition |
|||
Silvernanoparticles. |
Standard bavistin |
|||
0.50 mg/ml |
0.75 mg/ml |
0.60 mg/ml |
0.80 mg/ml |
|
Fusarium oxysprum |
45% |
59% |
45% |
57% |

Fig. 6: Shows photographs of antifungal effect of AgNPs against Fusarium oxysporum by well method
ACKNOWLEDGEMENT
The authors wish to thank to Gulbarga University, Gulbarga, Karnataka, India for providing Fellowship and also thankful to USIC and Physics departments (G. U. G) for UV spectrum and XRD analysis and IIT Mumbai for TEM analysis.
CONFLICT OF INTERESTS
Declared None
REFERENCES